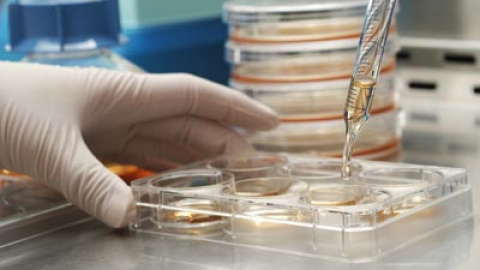

Este artículo se publicó hace 15 años.
La UE prohíbe patentar tratamientos con células embrionarias
Asociaciones católicas celebran la sentencia y los científicos creen que frenará la investigación
Los tratamientos o las investigaciones científicas que utilicen células madre embionarias no podrán ser patentados. Según una sentencia del Tribunal de Justicia de la UE, publicada este martes, "la investigación científica que implique el uso de embriones humanos no puede acogerse a la protección de la ley de patentes".
El fallo fue acogido con decepción por la comunidad científica por el riesgo de que frene el desarrollo de la investigación en Europa. El dictamen se basa en una interpretación amplia de la legislación, ya que extiende la protección de los denominados "embriones humanos" a todo óvulo fecundado. La sentencia incluye también los óvulos no fecundados pero en los que se hayan implantado partes de células maduras y los que son estimulados para desarrollarse de manera artificial.
El caso se remonta a 1997, cuando un científico, Oliver Bruestle, patentó un tratamiento para enfermedades neurológicas que incluía células madre. Según este académico de la Universidad de Bonn, el fallo "significa que la investigación básica puede hacerse en Europa, pero el desarrollo que sigue, no". En la práctica, serán "otros investigadores, en EEUU o Asia, los que recojan los frutos" de los avances nacidos en la UE. Aunque varias asociaciones cristianas recibieron con alegría el fallo, no fueron ellas las que denunciaron el registro de Bruestle, sino Greenpeace. "El tribunal dice que la ética es prioritaria a los intereses comerciales", aseguró Christoph Then, un responsable de la organización.
Según varios científicos, la sentencia es una amenaza a la investigación con células madre, ya que esta depende de que haya un retorno de la inversión en forma de tratamientos efectivos que puedan patentarse y comercializarse. Ian Wilmut, al frente del equipo que clonó a la oveja Dolly, aseguró que "hará mucho menos probable que las compañías en Europa inviertan en el desarrollo de nuevos tratamientos".
Para COMECE, una organización que agrupa a obispos y responsables católicos en la UE, la sentencia ofrece "una amplia, científica y seria definición de embrión humano". Las células madre son casi siempre extraídas en los primeros días tras la fecundación, cuando el embrión es de un tamaño minúsculo.
Comentarios de nuestros socias/os
¿Quieres comentar?Para ver los comentarios de nuestros socias y socios, primero tienes que iniciar sesión o registrarte.